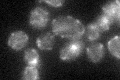
YKR036C
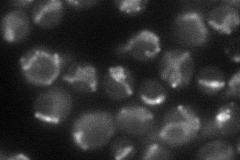
YKR036C
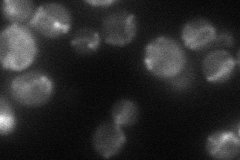
YKR036C
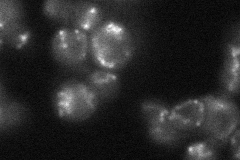
YKR036C
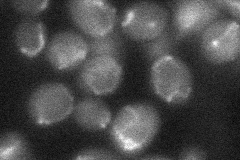
YKR036C

View description
WD40 repeat-containing protein associated with the CCR4-NOT complex, interacts in a Ccr4p-dependent manner with Ssn2p; also interacts with Fis1p, Mdv1p and Dnm1p and plays a role in mitochondrial fission
Localization:
Intensity:
Fold change:
Significance:
-
C’ GFP library in SD
mitochondria25.06 -
N' NOP1pr-GFP in SD
mitochondria54.9462 -
N' TEF2pr-mCherry in SD
mitochondria37.0868 -
N' NATIVEpr-GFP in SD
mitochondria31.7405 -
N' TEF2pr-VC and Cyto-VN in SD
punctate,mitochondria29.2589 -
C’ GFP library in SD+DTT

mitochondria22.80.9No -
C’ GFP library in SD+H2O2

mitochondria28.381.13No -
C’ GFP library in Starvation Media

mitochondria20.970.83No -
C’ GFP library on the background of Pup2-DaMP

mitochondria -
C’ GFP library on the background of CCT mutant

mitochondria25.95661.03563No
